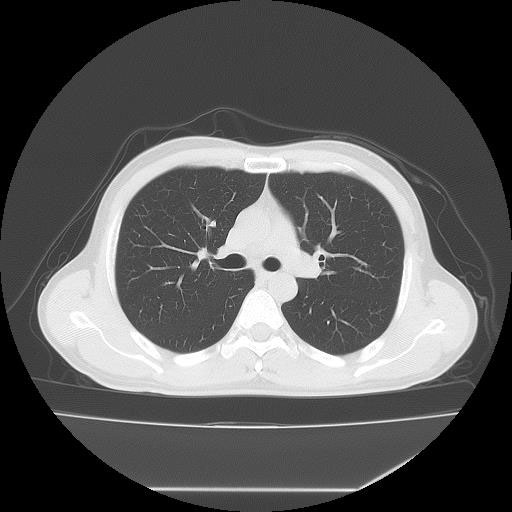
胸部CT検査1

CT検査の特徴
CT検査は様々な方向からX線を当て体内の水分や骨、空気など成分の違いを区別して画像を生成することで、レントゲン等では得ることができない臓器の状態を詳細に把握することが可能となり、小さい腫瘍などをより明確に映し出すことができます。
また、多角的に体内の断面図を得ることができるため立体的に構造を理解することが可能になり、病変の位置や広がりをより詳細に判断することが可能になります。
一方でX線を使用することになりますので、妊娠中の方や妊娠の可能性がある方は必ず医師にご相談下さい。ペースメーカーや除細動器を使用している方は照射範囲の調整が必要となるため、事前にご相談下さい。
当院で導入している富士フイルム社製64列CT(Supria Optica)ではAI機能搭載により、画質を維持したまま最大で80%程度被曝量を抑えた撮影が可能となります。瀬谷区に初めて導入された64列CT装置であり、大規模病院クラスで稼働している検査機器を身近にご利用頂けます。
CT装置は列数が多くなると一度に広範囲の撮影が可能となり、息止め時間が短くなるため少ない負担で検査を受けて頂けます。また、より細かい断層(輪切り)画像を撮る事ができ、病変の抽出能が上がることは早期発見に繋がります。
※現在当院では造影剤を用いたCT検査は行なっておりません。